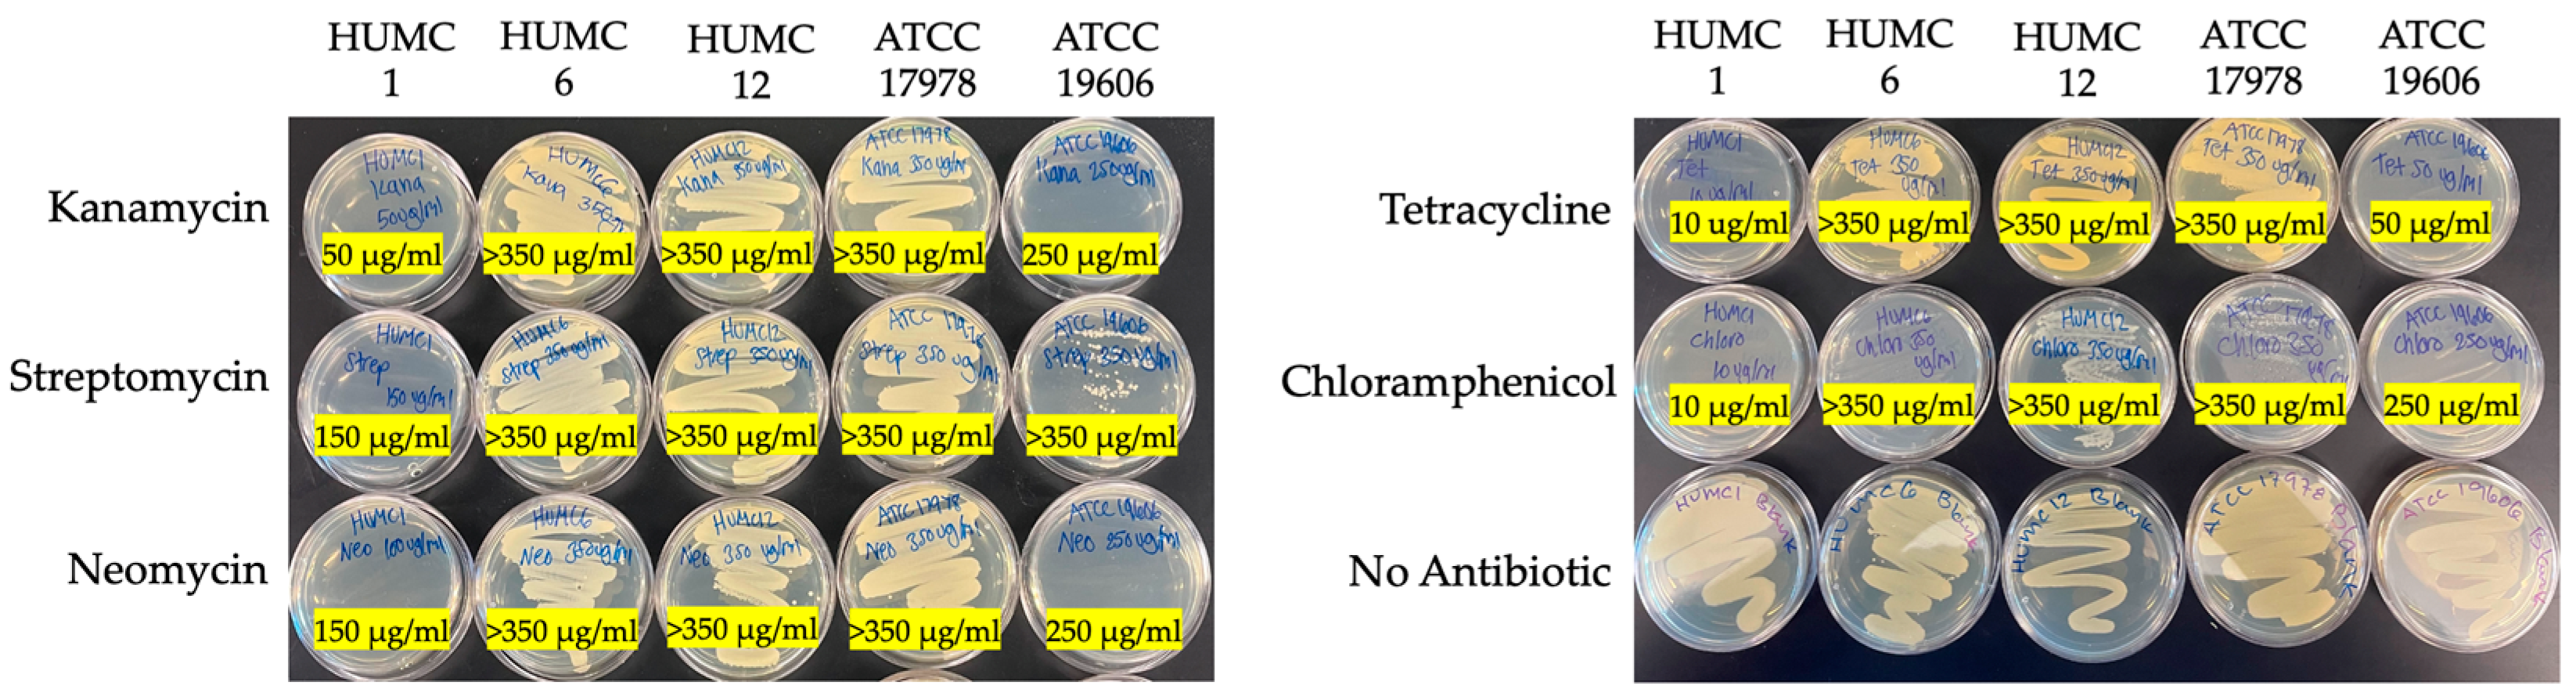
Ijms 25 09780 g001

The Comparative Characterization of a Hypervirulent Acinetobacter baumannii Bacteremia Clinical Isolate Reveals a Novel Mechanism of Pathogenesis
Abstract
1. Introduction
2. Results
2.1. Different Acinetobacter Baumannii Clinical Isolates Responded Differently to Antibiotic Treatment
2.2. Hypervirulent HUMC1 Clinical Isolate Does Not Form a Biofilm
2.3. The Hypervirulent HUMC1 Clinical Isolate Reached Twice the Cell Density When Compared to Its Counterparts
2.4. The Hypervirulent HUMC1 Clinical Isolate Does Not Shed Endotoxin into the Extracellular Milieu
2.5. The Hypervirulent HUMC1 Clinical Isolate Secretes an Exotoxin into the Extracellular Milieu
2.6. The Hypervirulent HUMC1 Clinical Isolate Secretes Zonula Occludens Toxin (Zot) into the Extracellular Milieu
2.7. The Activity of Zot Is Reversible
2.8. Phylogenetic Analysis of Numerous A. baumannii Genomes Reveals All Strains Tested Harbor the Gene Encoding Zonula Occludens Toxin
2.9. Protein Sequence Alignments and Structural Modeling of Zot Encoded by V. cholerae vs. A. baumannii Show a Low Degree of Amino Acid Sequence Identity with a High Degree of Structural Similarity
2.10. The Hypervirulent HUMC1 Clinical Isolate Is Fitter than Its Counterparts
3. Discussion
4. Materials and Methods
4.1. Strains
4.2. Antibiotic Resistance
4.3. Growth Kinetics
4.4. Endotoxin Shedding
4.5. Biofilm Quantification Assays
4.6. Heat Inactivation Experiments
4.7. Supernatant Fractionations and Microscopy
4.8. UniProt Database Mining
4.9. NCBI BLAST and MUSCLE Algorithm
4.10. Backtranslation
4.11. SWISS-MODEL
Funding
Institutional Review Board Statement
Informed Consent Statement
Data Availability Statement
Conflicts of Interest
References
- Perez, F.; Hujer, A.M.; Hujer, K.M.; Decker, B.K.; Rather, P.N.; Bonomo, R.A. Global challenge of multidrug-resistant Acinetobacter baumannii. Antimicrob. Agents Chemother. 2007, 51, 3471–3484. [Google Scholar] [CrossRef]
- Falagas, M.; Karveli, E.; Siempos, I.; Vardakas, K. Acinetobacter infections: A growing threat for critically ill patients. Epidemiol. Infect. 2008, 136, 1009–1019. [Google Scholar] [CrossRef] [PubMed]
- Hoffmann, M.S.; Eber, M.R.; Laxminarayan, R. Increasing resistance of Acinetobacter species to imipenem in United States hospitals, 1999–2006. Infect. Control Hosp. Epidemiol. 2010, 31, 196–197. [Google Scholar] [CrossRef] [PubMed]
- Maragakis, L.L.; Tucker, M.G.; Miller, R.G.; Carroll, K.C.; Perl, T.M. Incidence and prevalence of multidrug-resistant Acinetobacter using targeted active surveillance cultures. Jama 2008, 299, 2513–2514. [Google Scholar] [CrossRef] [PubMed]
- Aronson, N.E.; Sanders, J.W.; Moran, K.A. In harm’s way: Infections in deployed American military forces. Clin. Infect. Dis. 2006, 43, 1045–1051. [Google Scholar] [CrossRef]
- Scott, P.; Deye, G.; Srinivasan, A.; Murray, C.; Moran, K.; Hulten, E.; Fishbain, J.; Craft, D.; Riddell, S.; Lindler, L. An outbreak of multidrug-resistant Acinetobacter baumannii-calcoaceticus complex infection in the US military health care system associated with military operations in Iraq. Clin. Infect. Dis. 2007, 44, 1577–1584. [Google Scholar] [CrossRef]
- Murray, C.K.; Roop, S.A.; Hospenthal, D.R.; Dooley, D.P.; Wenner, K.; Hammock, J.; Taufen, N.; Gourdine, E. Bacteriology of war wounds at the time of injury. Mil. Med. 2006, 171, 826–829. [Google Scholar] [CrossRef]
- Sebeny, P.J.; Riddle, M.S.; Petersen, K. Acinetobacter baumannii skin and soft-tissue infection associated with war trauma. Clin. Infect. Dis. 2008, 47, 444–449. [Google Scholar] [CrossRef]
- Bulens, S.N.; Sarah, H.Y.; Walters, M.S.; Jacob, J.T.; Bower, C.; Reno, J.; Wilson, L.; Vaeth, E.; Bamberg, W.; Janelle, S.J. Carbapenem-nonsusceptible Acinetobacter baumannii, 8 US metropolitan areas, 2012–2015. Emerg. Infect. Dis. 2018, 24, 727. [Google Scholar] [CrossRef]
- Panahi, A.H.; Dehvan, F.; Naleini, S.N.; Rouhi, S.; Bechashk, S.M.; Darehbagh, R.R.; Derakhshan, S.; Jafarpour, H. Prevalence of Acinetobacter baumannii with multiple drug resistance isolated from patients with ventilator-associated pneumonia from 2010 to 2020 in the world: A systematic review and meta-analysis. Rev. Res. Med. Microbiol. 2024, 35, 23–35. [Google Scholar]
- Villar, M.; Cano, M.E.; Gato, E.; Garnacho-Montero, J.; Cisneros, J.M.; de Alegría, C.R.; Fernández-Cuenca, F.; Martínez-Martínez, L.; Vila, J.; Pascual, A. Epidemiologic and clinical impact of Acinetobacter baumannii colonization and infection: A reappraisal. Medicine 2014, 93, 202–210. [Google Scholar] [CrossRef] [PubMed]
- Karageorgopoulos, D.E.; Falagas, M.E. Current control and treatment of multidrug-resistant Acinetobacter baumannii infections. Lancet Infect. Dis. 2008, 8, 751–762. [Google Scholar] [CrossRef] [PubMed]
- Metan, G.; Alp, E.; Aygen, B.; Sumerkan, B. Carbapenem-resistant Acinetobacter baumannii: An emerging threat for patients with post-neurosurgical meningitis. Int. J. Antimicrob. Agents 2007, 29, 112–113. [Google Scholar] [CrossRef] [PubMed]
- Baran, G.; Erbay, A.; Bodur, H.; Öngürü, P.; Akıncı, E.; Balaban, N.; Çevik, M.A. Risk factors for nosocomial imipenem-resistant Acinetobacter baumannii infections. Int. J. Infect. Dis. 2008, 12, 16–21. [Google Scholar] [CrossRef] [PubMed]
- Kim, B.-N.; Peleg, A.Y.; Lodise, T.P.; Lipman, J.; Li, J.; Nation, R.; Paterson, D.L. Management of meningitis due to antibiotic-resistant Acinetobacter species. Lancet Infect. Dis. 2009, 9, 245–255. [Google Scholar] [CrossRef]
- Chopra, T.; Marchaim, D.; Awali, R.A.; Krishna, A.; Johnson, P.; Tansek, R.; Chaudary, K.; Lephart, P.; Slim, J.; Hothi, J. Epidemiology of bloodstream infections caused by Acinetobacter baumannii and impact of drug resistance to both carbapenems and ampicillin-sulbactam on clinical outcomes. Antimicrob. Agents Chemother. 2013, 57, 6270–6275. [Google Scholar] [CrossRef]
- Jiménez-Guerra, G.; Heras-Cañas, V.; Gutiérrez-Soto, M.; del Pilar Aznarte-Padial, M.; Expósito-Ruiz, M.; Navarro-Marí, J.M.; Gutiérrez-Fernández, J. Urinary tract infection by Acinetobacter baumannii and Pseudomonas aeruginosa: Evolution of antimicrobial resistance and therapeutic alternatives. J. Med. Microbiol. 2018, 67, 790–797. [Google Scholar] [CrossRef]
- Gu, Y.; Jiang, Y.; Zhang, W.; Yu, Y.; He, X.; Tao, J.; Hou, X.; Wang, H.; Deng, M.; Zhou, M. Risk factors and outcomes of bloodstream infections caused by Acinetobacter baumannii: A case–control study. Diagn. Microbiol. Infect. Dis. 2021, 99, 115229. [Google Scholar] [CrossRef]
- Ellis, D.; Cohen, B.; Liu, J.; Larson, E. Risk factors for hospital-acquired antimicrobial-resistant infection caused by Acinetobacter baumannii. Antimicrob. Resist. Infect. Control 2015, 4, 1–5. [Google Scholar] [CrossRef]
- Ma, C.; McClean, S. Mapping global prevalence of Acinetobacter baumannii and recent vaccine development to tackle it. Vaccines 2021, 9, 570. [Google Scholar] [CrossRef]
- Tacconelli, E.; Carrara, E.; Savoldi, A.; Harbarth, S.; Mendelson, M.; Monnet, D.L.; Pulcini, C.; Kahlmeter, G.; Kluytmans, J.; Carmeli, Y. Discovery, research, and development of new antibiotics: The WHO priority list of antibiotic-resistant bacteria and tuberculosis. Lancet Infect. Dis. 2018, 18, 318–327. [Google Scholar] [CrossRef]
- Ahmed, S.S.; Alp, E.; Hopman, J.; Voss, A. Global epidemiology of colistin resistant Acinetobacter baumannii. J. Infect. Dis. Ther. 2016, 4, 287. [Google Scholar]
- Castanheira, M.; Mendes, R.E.; Gales, A.C. Global epidemiology and mechanisms of resistance of Acinetobacter baumannii-calcoaceticus complex. Clin. Infect. Dis. 2023, 76 (Suppl. S2), S166–S178. [Google Scholar] [CrossRef] [PubMed]
- Karakonstantis, S.; Gikas, A.; Astrinaki, E.; Kritsotakis, E.I. Excess mortality due to pandrug-resistant Acinetobacter baumannii infections in hospitalized patients. J. Hosp. Infect. 2020, 106, 447–453. [Google Scholar] [CrossRef] [PubMed]
- Talbot, G.H. What is in the pipeline for Gram-negative pathogens? Expert Rev. Anti-Infect. Ther. 2008, 6, 39–49. [Google Scholar] [CrossRef]
- Boucher, H.W.; Talbot, G.H.; Bradley, J.S.; Edwards, J.E.; Gilbert, D.; Rice, L.B.; Scheld, M.; Spellberg, B.; Bartlett, J. Bad bugs, no drugs: No ESKAPE! An update from the Infectious Diseases Society of America. Clin. Infect. Dis. 2009, 48, 1–12. [Google Scholar] [CrossRef]
- Al-Tawfiq, J.A.; Momattin, H.; Al-Ali, A.Y.; Eljaaly, K.; Tirupathi, R.; Haradwala, M.B.; Areti, S.; Alhumaid, S.; Rabaan, A.A.; Al Mutair, A. Antibiotics in the pipeline: A literature review (2017–2020). In Infection; Springer: Berlin/Heidelberg, Germany, 2022; pp. 1–12. [Google Scholar]
- Prasad, N.K.; Seiple, I.B.; Cirz, R.T.; Rosenberg, O.S. Leaks in the pipeline: A failure analysis of gram-negative antibiotic development from 2010 to 2020. Antimicrob. Agents Chemother. 2022, 66, e00054-22. [Google Scholar] [CrossRef]
- Dijkshoorn, L.; Nemec, A.; Seifert, H. An increasing threat in hospitals: Multidrug-resistant Acinetobacter baumannii. Nat. Rev. Microbiol. 2007, 5, 939–951. [Google Scholar] [CrossRef]
- Harding, C.M.; Hennon, S.W.; Feldman, M.F. Uncovering the mechanisms of Acinetobacter baumannii virulence. Nat. Rev. Microbiol. 2018, 16, 91–102. [Google Scholar] [CrossRef]
- Benyamini, P. Phylogenetic Tracing of Evolutionarily Conserved Zonula Occludens Toxin Reveals a “High Value” Vaccine Candidate Specific for Treating Multi-Strain Pseudomonas aeruginosa Infections. Toxins 2024, 16, 271. [Google Scholar] [CrossRef]
- Bouvet, P.J.; Grimont, P.A. Taxonomy of the genus Acinetobacter with the recognition of Acinetobacter baumannii sp. nov., Acinetobacter haemolyticus sp. nov., Acinetobacter johnsonii sp. nov., and Acinetobacter junii sp. nov. and emended descriptions of Acinetobacter calcoaceticus and Acinetobacter lwoffii. Int. J. Syst. Evol. Microbiol. 1986, 36, 228–240. [Google Scholar]
- Baumann, P.; Doudoroff, M.; Stanier, R. A study of the Moraxella group II. Oxidative-negative species (genus Acinetobacter). J. Bacteriol. 1968, 95, 1520–1541. [Google Scholar] [CrossRef] [PubMed]
- Bruhn, K.W.; Pantapalangkoor, P.; Nielsen, T.; Tan, B.; Junus, J.; Hujer, K.M.; Wright, M.S.; Bonomo, R.A.; Adams, M.D.; Chen, W. Host fate is rapidly determined by innate effector-microbial interactions during Acinetobacter baumannii bacteremia. J. Infect. Dis. 2015, 211, 1296–1305. [Google Scholar] [CrossRef] [PubMed]
- Luna, B.M.; Ulhaq, A.; Yan, J.; Pantapalangkoor, P.; Nielsen, T.B.; Davies, B.W.; Actis, L.A.; Spellberg, B. Selectable markers for use in genetic manipulation of extensively drug-resistant (XDR) Acinetobacter baumannii HUMC1. Msphere 2017, 2, e00140-17. [Google Scholar] [CrossRef] [PubMed]
- Lucaßen, K.; Gerson, S.; Xanthopoulou, K.; Wille, J.; Wille, T.; Seifert, H.; Higgins, P. Comparison of the Acinetobacter baumannii reference strains ATCC 17978 and ATCC 19606 in antimicrobial resistance mediated by the AdeABC efflux pump. Antimicrob. Agents Chemother. 2021, 65, e00570-21. [Google Scholar] [CrossRef] [PubMed]
- Valentine, S.C.; Contreras, D.; Tan, S.; Real, L.J.; Chu, S.; Xu, H.H. Phenotypic and molecular characterization of Acinetobacter baumannii clinical isolates from nosocomial outbreaks in Los Angeles County, California. J. Clin. Microbiol. 2008, 46, 2499–2507. [Google Scholar] [CrossRef]
- Nadell, C.D.; Xavier, J.B.; Foster, K.R. The sociobiology of biofilms. FEMS Microbiol. Rev. 2008, 33, 206–224. [Google Scholar] [CrossRef]
- Lahiri, D.; Nag, M.; Ghosh, A.; Das, D.; Dey, A.; Mukherjee, D.; Garai, S.; Ray, R.R. Biofilm and antimicrobial resistance. Biofilm-Mediated Diseases: Causes and Controls; Springer: Berlin/Heidelberg, Germany, 2021; pp. 183–208. [Google Scholar]
- Mea, H.J.; Yong, P.V.C.; Wong, E.H. An overview of Acinetobacter baumannii pathogenesis: Motility, adherence and biofilm formation. Microbiol. Res. 2021, 247, 126722. [Google Scholar] [CrossRef]
- López-Martín, M.; Dubern, J.-F.; Alexander, M.R.; Williams, P. AbaM regulates quorum sensing, biofilm formation, and virulence in Acinetobacter baumannii. J. Bacteriol. 2021, 203, 10–1128. [Google Scholar] [CrossRef]
- Law, S.K.K.; Tan, H.S. The role of quorum sensing, biofilm formation, and iron acquisition as key virulence mechanisms in Acinetobacter baumannii and the corresponding anti-virulence strategies. Microbiol. Res. 2022, 260, 127032. [Google Scholar] [CrossRef]
- Nyström, T. Stationary-phase physiology. Annu. Rev. Microbiol. 2004, 58, 161–181. [Google Scholar] [CrossRef] [PubMed]
- Navarro Llorens, J.M.; Tormo, A.; Martínez-García, E. Stationary phase in gram-negative bacteria. FEMS Microbiol. Rev. 2010, 34, 476–495. [Google Scholar] [CrossRef] [PubMed]
- Ruiz, B.; Chávez, A.; Forero, A.; García-Huante, Y.; Romero, A.; Sánchez, M.; Rocha, D.; Sánchez, B.; Rodríguez-Sanoja, R.; Sánchez, S. Production of microbial secondary metabolites: Regulation by the carbon source. Crit. Rev. Microbiol. 2010, 36, 146–167. [Google Scholar] [CrossRef] [PubMed]
- Heumann, D.; Roger, T. Initial responses to endotoxins and Gram-negative bacteria. Clin. Chim. Acta 2002, 323, 59–72. [Google Scholar] [CrossRef]
- Opal, S.M. Endotoxins and other sepsis triggers. Endotoxemia Endotoxin Shock 2010, 167, 14–24. [Google Scholar]
- Fasano, A.; Baudry, B.; Pumplin, D.W.; Wasserman, S.S.; Tall, B.D.; Ketley, J.M.; Kaper, J. Vibrio cholerae produces a second enterotoxin, which affects intestinal tight junctions. Proc. Natl. Acad. Sci. USA 1991, 88, 5242–5246. [Google Scholar] [CrossRef]
- Fasano, A.; Fiorentini, C.; Donelli, G.; Uzzau, S.; Kaper, J.; Margaretten, K.; Ding, X.; Guandalini, S.; Comstock, L.; Goldblum, S. Zonula occludens toxin modulates tight junctions through protein kinase C-dependent actin reorganization, in vitro. J. Clin. Investig. 1995, 96, 710–720. [Google Scholar] [CrossRef]
- Di Pierro, M.; Lu, R.; Uzzau, S.; Wang, W.; Margaretten, K.; Pazzani, C.; Maimone, F.; Fasano, A. Zonula occludens toxin structure-function analysis: Identification of the fragment biologically active on tight junctions and of the zonulin receptor binding domain. J. Biol. Chem. 2001, 276, 19160–19165. [Google Scholar] [CrossRef]
- Akrami, F.; Namvar, A.E. Acinetobacter baumannii as nosocomial pathogenic bacteria. Mol. Genet. Microbiol. Virol. 2019, 34, 84–96. [Google Scholar] [CrossRef]
- Stanley, C.N.; Awanye, A.M.; Ogbonnaya, U.C. Acinetobacter baumannii: Epidemiology, Clinical Manifestations and Associated Infections. In Acinetobacter baumannii—The Rise of a Resistant Pathogen; Rangel, K., De-Simone, S., Eds.; IntechOpen: London, UK, 2023; pp. 1–23, Chapter 1; Available online: https://www.intechopen.com/chapters/1165986 (accessed on 1 August 2024).
- Tan, Y.C.; Lahiri, C. Promising Acinetobacter baumannii vaccine candidates and drug targets in recent years. Front. Immunol. 2022, 13, 900509. [Google Scholar] [CrossRef]
- Saipriya, K.; Swathi, C.; Ratnakar, K.; Sritharan, V. Quorum-sensing system in Acinetobacter baumannii: A potential target for new drug development. J. Appl. Microbiol. 2020, 128, 15–27. [Google Scholar] [CrossRef] [PubMed]
- Dollery, S.J.; Zurawski, D.V.; Bushnell, R.V.; Tobin, J.K.; Wiggins, T.J.; MacLeod, D.A.; Tasker, N.J.; Alamneh, Y.A.; Abu-Taleb, R.; Czintos, C.M. Whole-cell vaccine candidates induce a protective response against virulent Acinetobacter baumannii. Front. Immunol. 2022, 13, 941010. [Google Scholar] [CrossRef] [PubMed]
- Mardiana, M.; Teh, S.-H.; Tsai, Y.-C.; Yang, H.-H.; Lin, L.-C.; Lin, N.-T. Characterization of a novel and active temperate phage vB_AbaM_ABMM1 with antibacterial activity against Acinetobacter baumannii infection. Sci. Rep. 2023, 13, 11347. [Google Scholar] [CrossRef] [PubMed]
- Tillery, L.M.; Barrett, K.F.; Dranow, D.M.; Craig, J.; Shek, R.; Chun, I.; Barrett, L.K.; Phan, I.Q.; Subramanian, S.; Abendroth, J. Toward a structome of Acinetobacter baumannii drug targets. Protein Sci. 2020, 29, 789–802. [Google Scholar] [CrossRef] [PubMed]
- Gadar, K.; McCarthy, R.R. Using next generation antimicrobials to target the mechanisms of infection. npj Antimicrob. Resist. 2023, 1, 11. [Google Scholar] [CrossRef]
- Lowy, F.D. Staphylococcus aureus infections. New Engl. J. Med. 1998, 339, 520–532. [Google Scholar] [CrossRef]
- Mcloughlin, R. Bacterial Toxins: Offensive, Defensive, or Something Else Altogether? PLoS Pathog. 2017, 13, e1006452. [Google Scholar]
- Fasano, A. Toxins and the gut: Role in human disease. Gut 2002, 50 (Suppl. S3), iii9–iii14. [Google Scholar] [CrossRef]
- Michalska, M.; Wolf, P. Pseudomonas exotoxin A: Optimized by evolution for effective killing. Front. Microbiol. 2015, 6, 963. [Google Scholar]
- Popoff, M.R. Bacterial toxins, current perspectives. Toxins 2020, 12, 570. [Google Scholar] [CrossRef]
- do Vale, A.; Cabanes, D.; Sousa, S. Bacterial toxins as pathogen weapons against phagocytes. Front. Microbiol. 2016, 7, 42. [Google Scholar] [CrossRef]
- Barbieri, J.T.; Riese, M.J.; Aktories, K. Bacterial toxins that modify the actin cytoskeleton. Annu. Rev. Cell Dev. Biol. 2002, 18, 315–344. [Google Scholar] [CrossRef] [PubMed]
- Lubran, M.M. Bacterial toxins. Ann. Clin. Lab. Sci. 1988, 18, 58–71. [Google Scholar] [PubMed]
- Ramachandran, G. Gram-positive and gram-negative bacterial toxins in sepsis: A brief review. Virulence 2014, 5, 213–218. [Google Scholar] [CrossRef] [PubMed]
- Lemichez, E.; Barbieri, J.T. General aspects and recent advances on bacterial protein toxins. Cold Spring Harb. Perspect. Med. 2013, 3, a013573. [Google Scholar] [CrossRef]
- Henkel, J.S.; Baldwin, M.R.; Barbieri, J.T. Toxins from bacteria. Mol. Clin. Environ. Toxicol. Clin. Toxicol. 2010, 2, 1–29. [Google Scholar]
- Lucas, R.; Hadizamani, Y.; Gonzales, J.; Gorshkov, B.; Bodmer, T.; Berthiaume, Y.; Moehrlen, U.; Lode, H.; Huwer, H.; Hudel, M. Impact of bacterial toxins in the lungs. Toxins 2020, 12, 223. [Google Scholar] [CrossRef]
- Zhang, Y.; Yang, Z.; Gao, S.; Hamza, T.; Yfantis, H.G.; Lipsky, M.; Feng, H. The role of purified Clostridium difficile glucosylating toxins in disease pathogenesis utilizing a murine cecum injection model. Anaerobe 2017, 48, 249–256. [Google Scholar] [CrossRef]
- Jeong, Y.-J.; Park, S.-K.; Yoon, S.-J.; Park, Y.J.; Lee, M.-S. Experimental in vivo models of bacterial Shiga toxin-associated hemolytic uremic syndrome. J. Microbiol. Biotechnol. 2018, 28, 1413–1425. [Google Scholar] [CrossRef]
- Chiang, T.-T.; Huang, T.-W.; Sun, J.-R.; Kuo, S.-C.; Cheng, A.; Liu, C.-P.; Liu, Y.-M.; Yang, Y.-S.; Chen, T.-L.; Lee, Y.-T. Biofilm formation is not an independent risk factor for mortality in patients with Acinetobacter baumannii bacteremia. Front. Cell. Infect. Microbiol. 2022, 12, 964539. [Google Scholar] [CrossRef]
- Menon, D.; Karyekar, C.S.; Fasano, A.; Lu, R.; Eddington, N.D. Enhancement of brain distribution of anticancer agents using ΔG, the 12 kDa active fragment of ZOT. Int. J. Pharm. 2005, 306, 122–131. [Google Scholar] [CrossRef] [PubMed]
- Karyekar, C.S.; Fasano, A.; Raje, S.; Lu, R.; Dowling, T.C.; Eddington, N.D. Zonula occludens toxin increases the permeability of molecular weight markers and chemotherapeutic agents across the bovine brain microvessel endothelial cells. J. Pharm. Sci. 2003, 92, 414–423. [Google Scholar] [CrossRef] [PubMed]
- Lu, R.; Wang, W.; Uzzau, S.; Vigorito, R.; Zielke, H.; Fasano, A. Affinity purification and partial characterization of the zonulin/zonula occludens toxin (Zot) receptor from human brain. J. Neurochem. 2000, 74, 320–326. [Google Scholar] [CrossRef] [PubMed]
- Salama, N.N.; Eddington, N.D.; Fasano, A. Tight junction modulation and its relationship to drug delivery. Adv. Drug Deliv. Rev. 2006, 58, 15–28. [Google Scholar] [CrossRef]
- Zhang, X.; Wu, F.; Yang, N.; Zhan, X.; Liao, J.; Mai, S.; Huang, Z. In silico methods for identification of potential therapeutic targets. In Interdisciplinary Sciences: Computational Life Sciences; Springer: Berlin/Heidelberg, Germany, 2022; pp. 1–26. [Google Scholar]
- UniProt, C.U. The Universal Protein Knowledgebase in 2023. Nucleic Acids Res. 2023, 51, D523–D531. [Google Scholar] [CrossRef]
- Edgar, R.C. MUSCLE: Multiple sequence alignment with high accuracy and high throughput. Nucleic Acids Res. 2004, 32, 1792–1797. [Google Scholar] [CrossRef]
- Boratyn, G.M.; Camacho, C.; Cooper, P.S.; Coulouris, G.; Fong, A.; Ma, N.; Madden, T.L.; Matten, W.T.; McGinnis, S.D.; Merezhuk, Y. BLAST: A more efficient report with usability improvements. Nucleic Acids Res. 2013, 41, W29–W33. [Google Scholar] [CrossRef]
- Johnson, M.; Zaretskaya, I.; Raytselis, Y.; Merezhuk, Y.; McGinnis, S.; Madden, T.L. NCBI BLAST: A better web interface. Nucleic Acids Res. 2008, 36 (Suppl. S2), W5–W9. [Google Scholar] [CrossRef]
- Chojnacki, S.; Cowley, A.; Lee, J.; Foix, A.; Lopez, R. Programmatic access to bioinformatics tools from EMBL-EBI update: 2017. Nucleic Acids Res. 2017, 45, W550–W553. [Google Scholar] [CrossRef]
- Li, W.; Cowley, A.; Uludag, M.; Gur, T.; McWilliam, H.; Squizzato, S.; Park, Y.M.; Buso, N.; Lopez, R. The EMBL-EBI bioinformatics web and programmatic tools framework. Nucleic Acids Res. 2015, 43, W580–W584. [Google Scholar] [CrossRef]
- Schwede, T.; Kopp, J.; Guex, N.; Peitsch, M.C. SWISS-MODEL: An automated protein homology-modeling server. Nucleic Acids Res. 2003, 31, 3381–3385. [Google Scholar] [CrossRef] [PubMed]
- Waterhouse, A.; Bertoni, M.; Bienert, S.; Studer, G.; Tauriello, G.; Gumienny, R.; Heer, F.T.; de Beer, T.A.P.; Rempfer, C.; Bordoli, L. SWISS-MODEL: Homology modelling of protein structures and complexes. Nucleic Acids Res. 2018, 46, W296–W303. [Google Scholar] [CrossRef] [PubMed]

| Strain | HUMC1 | HUMC6 | HUMC12 | ATCC 17978 | ATCC 19606 |
|---|---|---|---|---|---|
| TSB | 0.32 | 3.7 × 103 | 3.6 × 103 | 3.7 × 103 | 3.5 × 103 |
| DMEMF12 + 10% TSB | 0.65 | 1.5 × 103 | 1.6 × 103 | 1.6 × 103 | 1.6 × 103 |
| DMEMF12 + 10% FBS | 0.34 | 1.8 × 103 | 1.7 × 103 | 1.6 × 103 | 1.8 × 103 |
Disclaimer/Publisher’s Note: The statements, opinions and data contained in all publications are solely those of the individual author(s) and contributor(s) and not of MDPI and/or the editor(s). MDPI and/or the editor(s) disclaim responsibility for any injury to people or property resulting from any ideas, methods, instructions or products referred to in the content. |
© 2024 by the author. Licensee MDPI, Basel, Switzerland. This article is an open access article distributed under the terms and conditions of the Creative Commons Attribution (CC BY) license (https://creativecommons.org/licenses/by/4.0/).
Share and Cite
Benyamini, P. The Comparative Characterization of a Hypervirulent Acinetobacter baumannii Bacteremia Clinical Isolate Reveals a Novel Mechanism of Pathogenesis. Int. J. Mol. Sci. 2024, 25, 9780. https://doi.org/10.3390/ijms25189780
Benyamini P. The Comparative Characterization of a Hypervirulent Acinetobacter baumannii Bacteremia Clinical Isolate Reveals a Novel Mechanism of Pathogenesis. International Journal of Molecular Sciences. 2024; 25(18):9780. https://doi.org/10.3390/ijms25189780
Chicago/Turabian StyleBenyamini, Payam. 2024. "The Comparative Characterization of a Hypervirulent Acinetobacter baumannii Bacteremia Clinical Isolate Reveals a Novel Mechanism of Pathogenesis" International Journal of Molecular Sciences 25, no. 18: 9780. https://doi.org/10.3390/ijms25189780
APA StyleBenyamini, P. (2024). The Comparative Characterization of a Hypervirulent Acinetobacter baumannii Bacteremia Clinical Isolate Reveals a Novel Mechanism of Pathogenesis. International Journal of Molecular Sciences, 25(18), 9780. https://doi.org/10.3390/ijms25189780
